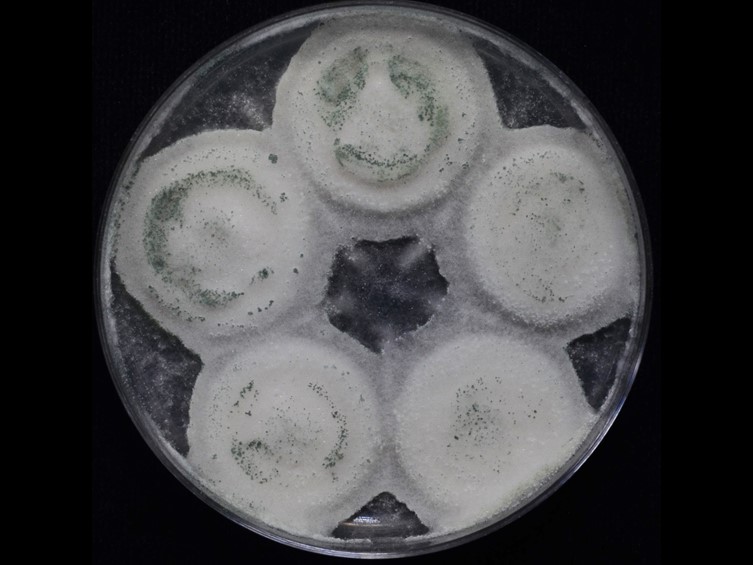

Holotype:
THAILAND, Pathum Thani Province, National Science and Technology Development Agency, BIOTEC Greenhouse, 2 Mar. 2012, C. Suriyachadkun, holotype BBH 32704, ex-type living culture BCC 51812.
Habitat:
Underside of rice leaves.
Host:
Bown planthoppers (Nilaparvata lugens; Delphacidae; Hemiptera).
Description:
 Host covered with white to smoke grey mycelium and powdery cream to smoke grey
Host covered with white to smoke grey mycelium and powdery cream to smoke grey  conidia.
conidia.  Phialides smooth-walled, cylindrical with semi-papillate apices, 5.5-12 × 2-3 μm. Conidia smooth-walled, cylindrical with rounded apices or ellipsoidal, 4-9 × 2-3 μm.
Phialides smooth-walled, cylindrical with semi-papillate apices, 5.5-12 × 2-3 μm. Conidia smooth-walled, cylindrical with rounded apices or ellipsoidal, 4-9 × 2-3 μm.
Culture characteristics:
Colonies on PDA attaining a diam of 21–22 mm in 20 d, mycelium dense, floccose, cottony, slightly convex to the agar surface, white turning to peacock-green, powdery while sporulating. Sporulation starts at 12 d after inoculation, reverse verona brown in the middle of colony and straw yellow with white cream at the margin. Conidiophores arising from aerial mycelia, erect, smooth-walled. Phialides smooth-walled, cylindrical with semi-papillate apices, 6–14 × 2–3 μm. Conidia smooth-walled, peacockgreen, ellipsoidal, 5–7 × 2–3 μm.
Colonies on PDA attaining a diam of 21–22 mm in 20 d, mycelium dense, floccose, cottony, slightly convex to the agar surface, white turning to peacock-green, powdery while sporulating. Sporulation starts at 12 d after inoculation, reverse verona brown in the middle of colony and straw yellow with white cream at the margin. Conidiophores arising from aerial mycelia, erect, smooth-walled. Phialides smooth-walled, cylindrical with semi-papillate apices, 6–14 × 2–3 μm. Conidia smooth-walled, peacockgreen, ellipsoidal, 5–7 × 2–3 μm.
Reference:
Mongkolsamrit S, Khonsanit A, Thanakitpipattana D, et al. (2020). Revisiting Metarhizium and the description of new species from Thailand. Studies in Mycology 95: 171–251.
DOI: https://doi.org/10.1016/j.simyco.2020.04.001Species |
Strain |
Compound |
Pubchem CID |
Biological activity |
Reference |
|---|
|
Strain |
ITS | LSU | RPB1 | RPB2 | SSU | TEF1 |
|---|---|---|---|---|---|---|
| BCC 51812 | MN781878 | MN781838 | MN781745 | MN781792 | MN781937 | MN781693 |
| BCC 51813 | MN781879 | MN781839 | MN781746 | MN781793 | MN781938 | MN781694 |